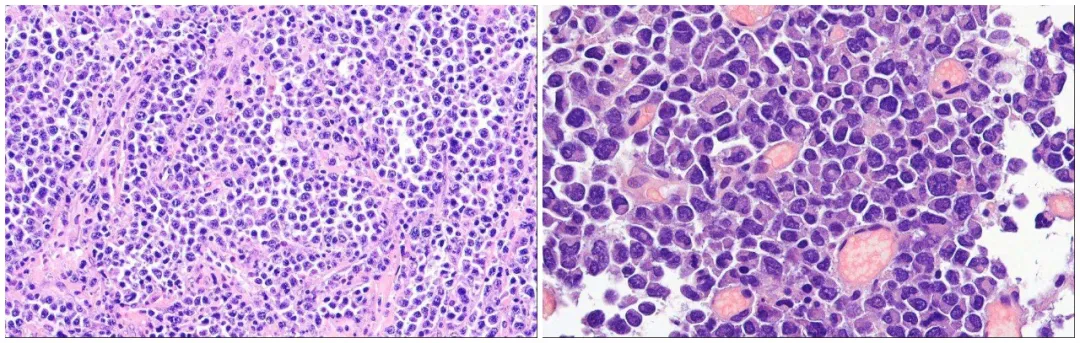

This study collected 72 cases of plasmablastic lymphoma from multiple institutions, which were reviewed and confirmed by hematopathology experts according to the World Health Organization classification criteria for lymphomas. Cases with a history of plasmacytoma or plasma cell myeloma, or those with plasma cell myeloma lesions at diagnosis, were excluded. Tissue microarrays were prepared from the relevant cases for further testing. For comparison, CK testing was also performed on 100 cases of definitively diagnosed diffuse large B-cell lymphoma, not otherwise specified.
The CK used in this study were CAM5.2 (CK8/18) and AE1/AE3. Specific product information (such as supplier, clone number, detection protocol, etc.), details of other antibodies used, and criteria for positivity determination can be found in the original article.
By definition, all plasmablastic lymphomas should express plasma cell-related markers. However, in this cohort, the positivity rates were 100% for IRF4/MUM1 (72/72), 80% for CD138 (57/71), and 85% for CD38 (60/71). Additionally, some cases expressed CD20 (positivity rate 14%, 10/72), CD19 (positivity rate 14%, 10/72), and PAX5 (positivity rate 17%, 12/72), generally with varying and mostly weak positivity. CD56 was expressed in 21 cases (30%, n=69), and IgG light chains were expressed in 36 cases (51%, n=70; with 12 cases expressing κ and 24 expressing λ).
EBV-specific mRNA in situ hybridization was positive in 42 cases (58%). Among 67 cases tested by FISH, 28 had MYC rearrangements, and MYC break-apart probe testing detected positivity in 24 cases (40%, n=60). Among 66 cases tested for MYC-IGH rearrangement, 18 were positive (27%); among 24 MYC-BAP positive cases, 18 (33%) were simultaneously MYC-IGH negative, suggesting different translocation partners. However, only 1 case among the MYC-IGH positive cases was simultaneously MYC-BAP negative.
Among other tested markers, the proportion negative for LCA/CD45 was 51% (36/71), while the proportion positive for CK8/18 was 15% (11/72), and for AE1/AE3 was 9% (6/65). All AE1/AE3 positive plasmablastic lymphomas were also CK8/18 positive. Generally, CK8/18 staining intensity was higher than AE1/AE3. Among 9 specimens where 10-40% of tumor cells expressed CK8/18, 3 did not express AE1/AE3. The staining pattern for CK8/18 was punctate, at least partially punctate in 8 out of 11 cases. All 6 AE1/AE3 positive cases showed punctate staining. This staining pattern resembles the CK positivity pattern seen in neuroendocrine carcinomas.
Further comparative analysis showed no significant differences between CK-positive and CK-negative cases in the expression of IRF4/MUM1, CD138, CD19, CD20, PAX5, κ and λ light chains, and CD38. Although CK-positive cases were more likely to be CD56 positive compared to CK-negative cases (6/11, 55% vs. 15/57, 26%), statistical analysis showed no significant difference (p=0.065).
The difference between CK-positive and CK-negative cases lies in their association with EBV: among 11 CK-positive cases, 2 (18%) were EBER positive, whereas among 61 CK-negative cases, 40 (66%) were EBER positive (p=0.001). No significant difference was observed in MYC rearrangements between CK-positive and CK-negative cases. Among 6 cases that were CK8/18 positive and simultaneously LCA/CD45 negative, all expressed plasma cell-related markers IRF4/MUM1, CD38, and CD138, but did not express B-cell characteristic markers CD19, CD20, or PAX5.
Among the 100 diffuse large B-cell lymphoma, not otherwise specified, cases used for comparison, all expressed LCA/CD45, and almost all cases showed uniform strong positivity. Only 1 out of 96 cases tested for CK8/18 and AE1/AE3 was positive, with positive cell counts of 80% and 50%, respectively, also showing punctate staining. Interestingly, upon review, this case showed immunohistochemical evidence of immunoblastic-plasmablastic differentiation, such as cytoplasmic IgM expression in almost all tumor cells and uniform strong CD20 positivity. In contrast, while plasmablastic lymphoma can have CD20 positivity, it is generally weak and only in a subset of tumor cells.
Figure 1. H&E appearance of plasmablastic lymphoma.

Figure2. Examples of positive CK8/18 (left) and AE1/AE3 (right) expression in plasmablastic lymphoma.

Figure 3. H&E appearance (top left) and immunohistochemical staining for CD20 (top right), CK8/18 (bottom left), and IgM (bottom right) of the only CK-positive diffuse large B-cell lymphoma case in this study.
For lymphomas, CK positivity is not common and is generally expressed in anaplastic large cell lymphoma or plasmacytoma, which may pose diagnostic challenges. Previous literature has reported cases of CK expression in plasmablastic lymphoma. If this occurs in extranodal sites, it is likely to be misdiagnosed as carcinoma.
According to this study, nearly one-sixth of plasmablastic lymphoma cases exhibit CK positivity, and nearly half of the cases do not express LCA/CD45. Combined with the fact that plasmablastic lymphoma often occurs in extranodal sites, it can easily be misdiagnosed as undifferentiated carcinoma. In such situations, if diffusely proliferating tumor cells show punctate or neuroendocrine-like CK staining, the possibility of a hematopoietic and lymphoid neoplasm, especially plasmablastic lymphoma, should be considered.
Related Antibodies from Maxin
|
Antibody Name
|
Product Code
|
Clone Number
|
Positive Localization
|
|
CD19*
|
MAB-0705
|
MX016
|
Cell Membrane
|
|
CD20
|
Kit-0001
|
L26
|
Cell Membrane
|
|
CD38*
|
MAB-0755
|
MX044
|
Cell Membrane |
| CD56* |
MAB-0743
|
MX039
|
Cell Membrane |
|
CD138
|
MAB-0200 |
MI15 |
Cell Membrane/Cytoplasm |
| MUM1* |
MAB-0885 |
MX093 |
Nucleus
|
| MUM1 |
MAB-0573
|
MUM1p |
Nucleus
|
*Indicates Maxin clone product
References
Huettl KS, Staiger AM, Horn H, et al. Cytokeratin Expression in Plasmablastic Lymphoma – a Possible Diagnostic